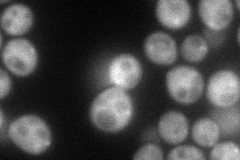
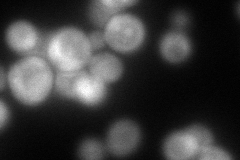
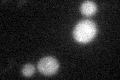
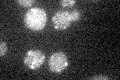

View description
One of 10 subunits of the transport protein particle (TRAPP) complex of the cis-Golgi which mediates vesicle docking and fusion; involved in endoplasmic reticulum (ER) to Golgi membrane traffic
Localization:
Intensity:
Fold change:
Significance:
-
C’ GFP library in SD

punctate19.81 -
N' NOP1pr-GFP in SD
cytosol,punctate93.2799 -
N' TEF2pr-mCherry in SD
cytosol,punctate96.2787 -
N' NATIVEpr-GFP in SD

punctate24.4902 -
N' TEF2pr-VC and Cyto-VN in SD

#N/A0 -
C’ GFP library in SD+DTT
punctate18.030.9No -
C’ GFP library in SD+H2O2

punctate18.610.93No -
C’ GFP library in Starvation Media
punctate20.291.02No -
C’ GFP library on the background of Pup2-DaMP

punctate -
C’ GFP library on the background of CCT mutant

punctate17.63390.889739No
